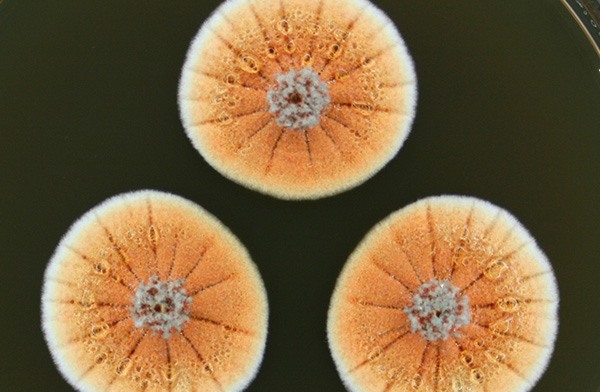

Биологический «ТОП-10» – аналитический портал ПОЛИТ.РУ

 Олингито Mark Gurney
Олингито Mark Gurney Международный институт исследования видов (International Institute for Species Exploration) при Аризонском университете опубликовал список десяти самых замечательных видов, описанных биологами за прошедший год (Top 10 New Specie). По традиции список публикуется 23 мая, в день рождения знаменитого систематика живой природы Карла Линнея, или накануне, 22 мая, когда отмечается Международный день биологического разнообразия.
За год биологи открыли более 18 тысяч новых видов, так что отборочному комитету было над чем работать. В итоговую десятку попали семь животных и по одному представителю царств грибов, растений и бактерий.
 Олингито. Фото: Mark Gurney
Олингито. Фото: Mark Gurney Млекопитающие в списке представлены олингито (Bassaricyon neblina) из Эквадора, первым новым видом отряда хищных, обнаруженным в западном полушарии за 35 лет. Он относится к семейству енотовых. Сперва он был обнаружен в музейных коллекциях: Кристофер Хелджен (Kristofer Helgen), куратор отдела млекопитающих в Национальном музее естественной истории в Вашингтоне, изучая хранившиеся в различных музеях экземпляры представителей рода Bassaricyon, пришел к выводу, что некоторые относятся к неописанному ранее виду. Так как эти животные были несколько меньше, чем другой вид – олинго, их стали называть олингито. В 2006 году Хелджену удалось наблюдать олингито в природе, во время экспедиции в Эквадор. Но официально новый вид был признан лишь в августе 2013 года, когда были изучены образцы его ДНК. Об открытии олингито уже рассказывалось в рубрике ProScience.
 Драцена Кавеесака. Фото: Paul Wilkin
Драцена Кавеесака. Фото: Paul Wilkin В список вошло растение рода драцена, получившее название драцена Кавеесака (Dracaena kaweesakii), название «звучит как что-то из «Игры престолов» - отмечает составитель пресс-релиза. Это дерево, достигающее 12-метровой высоты. Оно растет в известняковых горах провинций Лей и Лопбури в Таиланде, а также, возможно, в сопредельных районах Мьянмы. Название новому виду описавшие его биологи дали в честь своего коллеги, тайского ученого Кеераткиата Кавеесака (Keeratkiat Kaweesak). По оценке ученых, насчитывается всего около 2500 таких деревьев.
 Edwardsiella andrillae. Фото: SCINI
Edwardsiella andrillae. Фото: SCINI О новом виде актинии Edwardsiella andrillae вы также могли уже прочитать на страницах ProScience. Напомним, что он был обнаружен роботом, исследовавшим нижнюю поверхность шельфового ледника Росса в Антарктиде. Получив сделанные роботом фотографии, ученые увидели множество белых актиний, прикрепившихся к нижней поверхности ледника и свесивших щупальца в воду. Название вид получил в честь проекта изучение антарктических льдов ANDRILL (Antarctic Drilling Project).
 Liropus minusculus. Фото: SINC/J.M. Guerra-García
Liropus minusculus. Фото: SINC/J.M. Guerra-García Крошечная креветка с прозрачным телом Liropus minusculus была найден в водах пещеры на острове Санта-Каталина, недалеко от побережья Южной Калифорнии. Это первый представитель своего рода в бассейне Тихого океана. Размер тела самца этой креветки всего 3,3 миллиметра, самки – 2,1 миллиметра. Из-за прозрачности она получила английское название Skeleton Shrimp «скелетная креветка».
Колонии Penicillium vanoranjei. Фото: Cobus M. Visagie, Jan Dijksterhuis
Колонии Penicillium vanoranjei. Фото: Cobus M. Visagie, Jan Dijksterhuis Редкий гость в списках самых замечательных видов года – новый вид грибов. Им стал представитель знаменитого рода Penicillium, подарившего человечеству антибиотик пенициллин. Живет новый гриб Penicillium vanoranjei в почве Туниса, а открыт был нидерландскими учеными, так что его название, содержащее нидерландское слово oranje «оранжевый», не только отражает ярко-оранжевый цвет колоний гриба, но и отдает дань правящей в Нидерландах Оранской королевской династии. Буква VA в начале видового названия – ничто иное, как инициалы Виллема-Александра, ставшего 30 апреля новым королем Нидерландов после ухода на пенсию королевы Беатрикс.
 Saltuarius eximius. Фото: Conrad Hoskin
Saltuarius eximius. Фото: Conrad Hoskin Геккон Saltuarius eximius живет в горных тропических лесах хребта Мелвилл на северо-востоке Австралии. Обнаружить его трудно, так как он ловко маскируется при помощи пестрой раскраски и похожего на лист хвоста.
 Spiculosiphon oceana. Фото: Manuel Maldonado
Spiculosiphon oceana. Фото: Manuel Maldonado Хотя Spiculosiphon oceana имеет в длину всего 4–5 сантиметров, его вполне можно назвать гигантом, ведь этот вид относится к одноклеточным организмам. Он был обнаружен Средиземном море, в подводных пещерах в 30 милях от юго-восточного побережья Испании. Необычный облик этого существа привел к тому, что биологи первоначально приняли его за многоклеточное животное из типа губок. Как оказалось, губки действительно ему не чужды, ведь свой известковый скелет Spiculosiphon oceana создает из лежащих на дне спикул – скелетных элементов мертвых губок. Он приклеивает спикулы к своей оболочки особым веществом, просовывает в оставшиеся отверстия свои ложноножки и охотится на более мелких одноклеточных существ. Видовое название дано в честь некоммерческой организации Oceana, представители которой участвовали в экспедиции, открывшей этот вид.
 Tersicoccus phoenicis. Фото: California Institute of Technology/Leibniz-Institute DSMZ/California State University
Tersicoccus phoenicis. Фото: California Institute of Technology/Leibniz-Institute DSMZ/California State University Tersicoccus phoenicis стал третьим за историю публикации списков видом бактерий, удостоенным такой чести. Заслужил он это тем, что был обнаружен там, где вообще не должно быть никакой жизни. В помещениях, где готовят космические аппараты к запуску. Опасаясь занести в космос земных бактерий, специалисты проводят манипуляции в стерильных условиях, однако эта бактерия оказалась устойчивой к применявшимся методам стерилизации. Сначала ее обнаружили в Космическом центре имени Кеннеди, возле мыса Канаверал, во время подготовки космического аппарата «Феникс» (отсюда видовое название). Затем тот же вид был найден в «чистой комнате» Гвианского космического центра (космодром Куру), когда там готовили космическую обсерваторию «Гершель».
 Tinkerbella nana, растровая электронная микроскопия. Фото: Jennifer Read
Tinkerbella nana, растровая электронная микроскопия. Фото: Jennifer Read Еще один вид – Tinkerbella nana, насекомое-наездник из семейства Mymaridae – был кратко упомянут, когда мы говорили о названиях животных, взятых из художественной литературы. Обитает он в лесах Коста-Рики и является не только самым маленьким представителем своего рода (заметим из 1400 входящих в этот род видов), но и одним из самых маленьких насекомых. Длина его всего лишь 250 микрометров (0,25 мм). Пока еще неизвестно, какое насекомое служит этому наезднику для откладки яиц.
 Zospeum tholussum. Фото: Jana Bedek
Zospeum tholussum. Фото: Jana Bedek Наконец, в список вошла улитка Zospeum tholussum, обитающая в Хорватии, в системе пещер Лукина Яма – Трояма. Она живет на глубине около 900 метров и лишена глаз, ненужных в подземной тьме. Лишена она также и пигментации, что придает полупрозрачной улитке вид привидения. Длина улитки 2 мм, ползает она очень медленна, преодолевая не более сантиметра в неделю. Исследователи предполагают, что для путешествий на большие расстояния она пользуется попутным транспортом – пещерными сверчками или летучими мышами, или просто плывет в воде поземных ручейков.
Места обитания видов, вошедших в десятку, можно посмотреть на Google Maps.
Смотрите также: Открыт новый вид тапира Молекулярный анализ помог открыть новый вид белозубки из Вьетнама В Китае обнаружили ночную бабочку с солнцами на крыльях Российские ученые нашли в озере Восток неизвестный вид бактерий